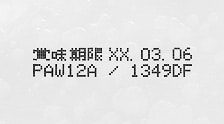

耐アルコール 強接着
MEKフリーインク新登場
産業用インクジェットプリンタ
MK-Gシリーズ

アルコールを吹きかけても
にじみなし
[ 耐アルコール ]
従来のMEKフリーインクは高濃度アルコールを吹きかけるとインクがにじんでしまいました。新インクはインク成分を見直すことで耐アルコール性を持たせました。
従来インク

アルコールをかけると、にじんでしまう
新インク
アルコールをかけても、にじまない
擦れても、かすれない
[ 強接着 ]
耐アルコール性だけでなく、高い接着力があります。 印字した直後に性能を発揮するので、後の工程でアルコールが付いたり、印字が擦れることがあっても安心です。
従来インク

接着力が弱い
新インク

接着力が強い
 詳しくは、ぜひカタログをダウンロード
詳しくは、ぜひカタログをダウンロード
してご確認ください。
お気軽にお電話ください
0120-716-516
受付時間 8:30~20:00(土日・祝日除く)
